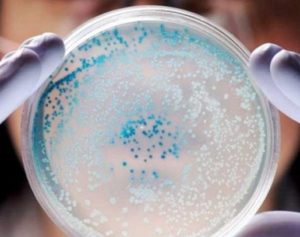
image

Что такое спермограмма и для чего она нужна?
Анализ спермы позволяет определить уровень плодовитости мужчины. Даже если у него нет проблем со здоровьем, перед зачатием рекомендуется сдать этот анализ, чтобы убедиться, что все в порядке. Обычно он выполняется при подозрении на мужское бесплодие. Сперма собирается в специальном контейнере, который герметично закрывается. В лаборатории проводятся следующие исследования:
- объем собранного материала;
- подвижность сперматозоидов;
- вязкость спермы;
- агглютинация (слипание);
- количество красных и белых кровяных клеток и другие показатели.
Если все показатели находятся в пределах нормы, это свидетельствует о нормальной плодовитости. Однако, если хотя бы один или несколько показателей отклоняются от нормы, спермограмму следует повторить. Это необходимо для выяснения, как внешние факторы влияют на качество и свойства спермы, а также для определения истинной плодовитости.
Где и как правильно ее сдавать?
Сдача спермограммы требует посещения медучреждения, где семя собирается путем мастурбации. В частных клиниках обычно предоставляются специальные помещения для этой процедуры, где мужчина может находиться в одиночестве и расслабиться. Возможно предоставление журналов или видео эротического характера для стимуляции. Однако, каждая клиника имеет свои особенности.
Крайне рекомендуется сдавать сперму именно в медучреждении, чтобы получить максимально точные результаты исследования. Многих мужчин смущает необходимость сдавать свой биоматериал прямо в клинике, поэтому они интересуются возможностью сбора спермы в домашних условиях и доставки ее в контейнере. Это возможно, однако, существует риск получения неправильных результатов анализа. Сперму нельзя перегревать, переохлаждать или держать слишком долго, даже при комнатной температуре. Хотя сдача спермы в больнице может быть не самой приятной процедурой, результаты будут максимально достоверными.
Сдача спермограммы не происходит в день обращения. Сотрудники медицинского центра должны подробно объяснить клиенту, как подготовиться к процедуре. Это важно для получения максимально достоверных данных о качестве спермы. Подготовка к сдаче спермограммы включает:
- Воздержание от половых контактов и мастурбации за 3-4 дня до сдачи спермы, чтобы собрать большой объем спермы.
- Избегание горячих ванн, саун и бань.
- Не принимать лекарства, за исключением жизненно важных препаратов, и не употреблять алкогольные напитки.
Для получения максимально достоверной информации о фертильности мужчины рекомендуется провести спермограмму как минимум 3 раза.
Сдача анализа спермограммы осуществляется в основном в частных клиниках. В поликлиниках также возможно сдать анализ, но не везде и могут быть проблемы с очередью или другие препятствия.
Сколько стоит проведение исследования?
Стоимость проведения спермограммы может варьироваться в зависимости от города, региона и клиники, где она выполняется. В среднем, этот анализ обойдется в 1500-2000 рублей. Однако, возможно, потребуется оплатить дополнительные анализы, такие как биохимический анализ эякулята, стоимостью примерно 700-1000 рублей, или MAR-тест, который может стоить от 2000 до 2500 рублей. Важно помнить, что спермограмма должна быть сдана как минимум 3 раза, поэтому эти расходы нужно умножить на 3 или даже больше.
Как улучшить качество спермы для зачатия?
Запланированное зачатие является разумным решением, которое принимают ответственные и зрелые люди. Даже если кажется, что нет проблем, лучше пройти проверку, чтобы быть уверенным в этом. Даже если серьезных проблем нет, все равно можно улучшить качество спермы в подготовке к зачатию. Ведь к беременности должны готовиться оба родителя, так как они оба вносят вклад в здоровье будущего ребенка.
Существует несколько способов улучшить спермограмму. За полгода-год до планируемого зачатия мужчина должен изменить свой образ жизни: отказаться от курения, алкоголя и других вредных привычек. Он должен больше отдыхать, меньше нервничать и избегать стрессовых ситуаций. Важное значение имеет также правильное питание. Желательно исключить фаст-фуд, вредные полуфабрикаты из магазина, газированные напитки и другую неполезную пищу, и переключиться на здоровую. Вначале это может быть сложно, но потом она покажется очень вкусной. Мужчине, так же как и женщине, необходимо принимать специальные витаминно-минеральные комплексы, чтобы улучшить качество спермы. Все это повысит шансы на зачатие и рождение здорового ребенка.
Какие могут возникнуть сложности при проведении процедуры?
Мужчинам часто бывает трудно сдать сперму из-за нервозности и стеснения. Однако важно понимать, что нет ничего постыдного в этом процессе. Мужчина находится в закрытом помещении, где никто не сможет его видеть или снимать на камеру. Сотрудники клиники, которые занимаются сбором спермы, относятся к этому процессу профессионально и без презрения. Многие мужчины приходят в клинику для сдачи спермы с целью проверить свое здоровье. Поэтому важно расслабиться, не стесняться и не бояться этой процедуры, особенно учитывая, что ее придется повторять несколько раз. Если вам интересно, как правильно сдавать сперму для спермограммы, вы можете узнать подробности в видео.